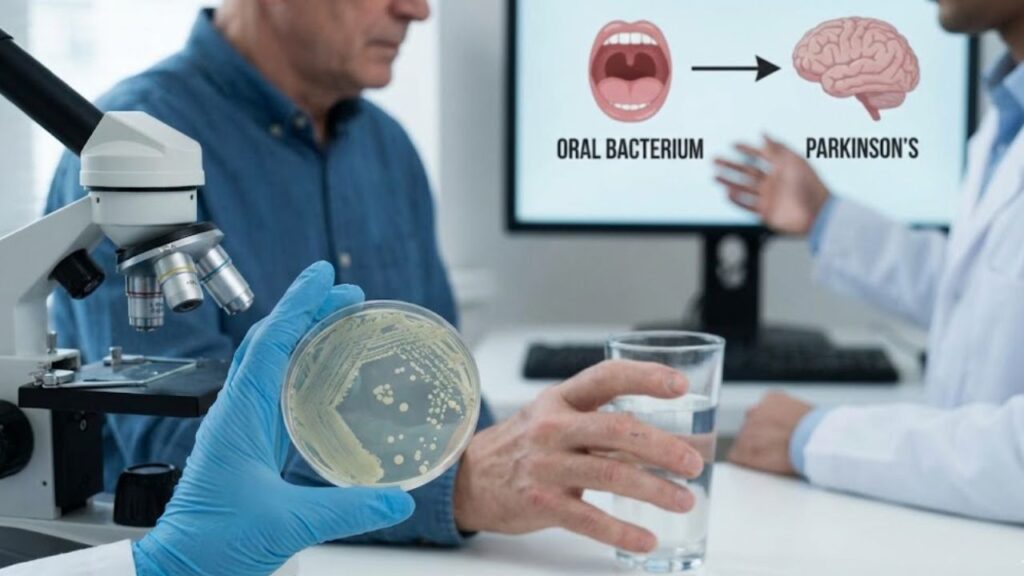

It’s early, the kind of early where the house is still holding its breath. The clock on the wall says 6:12 a.m. You stand at the sink, toothbrush in hand, not really thinking about much at all. This is one of those movements your body remembers without asking your mind for permission.
The mirror shows a familiar face, slightly softer around the edges than it once was. You rinse, spit, wipe your mouth, and move on. It’s a small, ordinary act. One you’ve done tens of thousands of times. Nothing about it feels important enough to linger on.
And yet, later in the day, a headline passes by. It mentions Parkinson’s disease and an oral bacterium—something common, something quiet, something that lives where you never thought to look twice. The words stay with you longer than expected.
The Subtle Feeling of Being Out of Step
As the years add up, you start to notice how often the world feels just a half-beat ahead of you. Not in a dramatic way. More like missing the start of a conversation, or needing a moment longer to find the right word.
You feel fine, mostly. But there’s a growing awareness that your body has its own timing now. Recovery takes longer. Sensations linger. Small changes feel more noticeable than they once did.
When you read about neurological conditions, it isn’t panic that rises. It’s recognition. Not of symptoms, but of vulnerability. The understanding that health isn’t just about what happens suddenly, but about what unfolds quietly, over time.
Why the Mouth Is Entering the Conversation
For years, Parkinson’s disease was talked about almost entirely as a brain condition. Something that appeared there, stayed there, and progressed there. The rest of the body felt like background scenery.
More recently, researchers have started paying attention to pathways instead of single locations. How different parts of the body communicate. How signals travel. How inflammation or imbalance in one place might ripple outward.
This is where the mouth enters the story. Not as a cause, not as a culprit, but as a possible participant in a much larger system.
Some studies have found that a well-known oral bacterium—one commonly associated with gum disease—appears more often in people living with Parkinson’s. The connection is still being explored, carefully and slowly. No certainty. No final answers. Just patterns that are hard to ignore.
A Small Story That Makes It Real
Rajiv, 62, didn’t think much about his gums. He brushed once a day, sometimes twice. Dental visits slipped further apart after retirement. Life felt full enough without adding another appointment.
When his hands began to tremble slightly, it was easy to blame stress, then age. Only later, after a diagnosis, did he hear about the research linking oral health and neurological conditions. It didn’t feel frightening to him. It felt oddly grounding.
“It made the body feel more connected,” he said. “Less like something betrayed me. More like something had been asking for attention for a long time.”
What May Be Happening, In Simple Terms
Your mouth isn’t just teeth. It’s a living environment. Bacteria live there naturally, many of them helpful, some of them problematic when balance shifts.
When gum disease develops, certain bacteria can increase and linger. This can lead to long-term, low-grade inflammation. Not the kind that hurts sharply, but the kind that hums quietly in the background.
Some scientists believe that this ongoing inflammation may influence the nervous system over many years. Others are studying whether these bacteria, or the body’s response to them, could travel along nerve pathways connected to the brain.
None of this means brushing your teeth wrong leads to Parkinson’s. It means the body may remember more than we once thought. It may respond to long-term signals in ways that only become visible later.
The idea isn’t blame. It’s context.
Living With Information Without Carrying Fear
At this stage of life, you’ve gathered enough experience to know that information can land in different ways. Some facts feel heavy. Others feel oddly relieving.
This kind of research doesn’t demand action. It invites understanding. It suggests that health isn’t a series of isolated systems, but a conversation happening all the time inside you.
And conversations, even quiet ones, can be listened to without urgency.
Gentle Adjustments That Respect Your Rhythm
Nothing here needs to be overhauled. No new rules. No strict regimes. Just small acts of awareness that fit into the life you already have.
- Noticing your mouth as part of your overall wellbeing, not a separate task.
- Letting dental check-ins feel like maintenance, not correction.
- Paying attention to signs of discomfort instead of brushing them aside.
- Allowing routines to become slower, more intentional, without guilt.
- Seeing daily care as continuity, not prevention.
A Thought That Feels Lived In
“I used to think health was about stopping bad things from happening. Now it feels more like staying in relationship with my body, even when it speaks softly.”
Reframing What This Knowledge Offers
Learning about possible links between oral bacteria and Parkinson’s disease doesn’t rewrite your future. It reframes the present.
It suggests that the small, ordinary moments—the rinse at the sink, the pause before bed, the quiet care you give without applause—have always mattered. Not because they prevent something terrible, but because they keep the conversation going.
Aging, in many ways, is about listening longer. About accepting that understanding replaces control. That connection replaces certainty.
You don’t need to fix your body. You don’t need to fear it. You’re already living inside a system that adapts, responds, and carries memory with remarkable patience.
This research doesn’t ask you to change who you are. It simply offers another way to see how deeply connected you’ve always been.
Key Takeaways at a Glance
| Key point | Detail | Value for the reader |
|---|---|---|
| Body systems are connected | Oral health may interact with neurological processes over time | Encourages a whole-body view without fear |
| Research is still evolving | Links are being studied, not declared as causes | Reduces anxiety and avoids oversimplification |
| Small routines matter | Everyday care supports long-term balance | Offers reassurance through familiarity |
